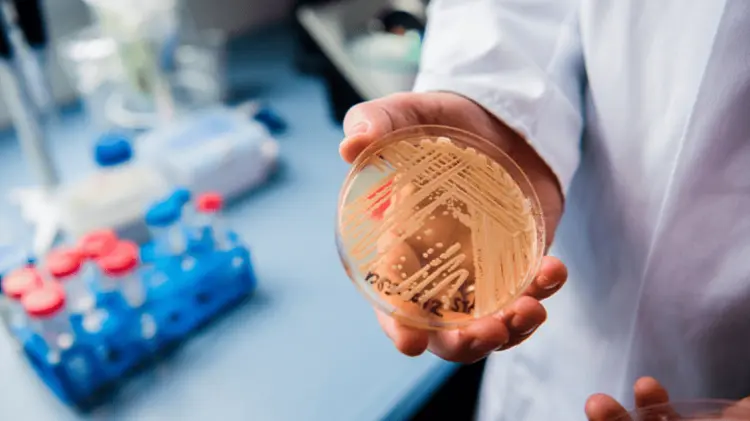

Mortal hongo se expande en EU: Candida Auris, ¿Qué es y cómo se contagia?
El hongo Candida Auris se ha convertido en una amenaza urgente de resistencia a los antimicrobianos en Estados Unidos, lo que representa una grave amenaza para la salud mundial.
El hongo Candida Auris causa preocupación por su rápida propagación y alta mortalidad en los centros de salud en Estados Unidos.
Según un estudio publicado en la revista "Annals of Internal Medicine", este hongo resistente a los medicamentos ya está presente en más de la mitad de los estados de Estados Unidos y casi la mitad de los infectados han muerto en pocos meses.
El hongo se propaga por tocar superficies u objetos contaminados, así como de persona a persona, y se produce principalmente en hospitales y hogares de la tercera edad en personas inmunodeprimidas o que reciben tratamientos invasivos para otras enfermedades.
Los síntomas comunes incluyen fiebre y escalofríos que persisten incluso con tratamiento antibiótico, pero el diagnóstico solo se puede confirmar mediante una muestra de sangre.
Desde que se documentó la primera infección en Japón en 2009, este hongo se ha expandido a muchos otros países, incluido Estados Unidos, donde se confirmó el primer caso en 2016.
Los Centros para el Control y Prevención de Enfermedades advierten que representa una grave amenaza para la salud mundial y el aumento del porcentaje de crecimiento de las infecciones con Candida auris, del 44% en 2019 al 95% en 2021, puede estar relacionado con las dificultades que la pandemia de COVID-19 ha producido en el sistema sanitario.